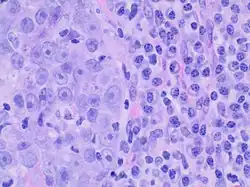

Medullary breast carcinoma
| Medullary carcinoma of the breast | |
|---|---|
_(14756739992).jpg) | |
| Specialty | Oncology, pathology |
Medullary breast carcinoma is a rare type of breast cancer[1] that is characterized as a relatively circumscribed tumor [2] with pushing, rather than infiltrating, margins. It is histologically characterized as poorly differentiated cells with abundant cytoplasm and pleomorphic high grade vesicular nuclei.[3] It involves lymphocytic (a type of white blood cell) infiltration[4] in and around the tumor and can appear to be brown in appearance with necrosis and hemorrhage.[5] Prognosis is measured through staging but can often be treated successfully and has a better prognosis than other infiltrating breast carcinomas.
Medullary breast carcinoma is one of five types of epithelial breast cancer: ductal, lobular, medullary, colloid, and tubular. Very rare cases of it have been diagnosed in men (see male breast cancer).[6]
Ductal Carcinoma in situ (DCIS) is less commonly present, and medullary breast cancer presents as a soft, fleshy mass with a pushing border. Tumors commonly possess mutations of E-cadherin, which results in its overexpression. Strengthened adhesions between tumor cells reduce the frequency of metastasis.
Epidemiology
It tends to occur more often in younger women and is more frequently found in those with BRCA1 gene mutations. Although this breast carcinoma is more frequently found in BRCA 1 gene mutations, most individuals with BRCA 1 gene mutations do not have medullary breast carcinoma.[7] Medullary breast carcinoma is rare and can be seen in about less than 5% of invasive breast cancers. Due to the complicated nature of classification, there are difficulties in subtyping this type of breast cancer.[5]
Diagnosis
Criteria must be met through the Ridolfi criteria. Although there are other classifications for diagnosis, the Ridolfi criteria are the most commonly used. There must be histologic evidence of lymphoplasmacytic infiltration, noninvasive microscopic circumscription, greater than 75% syncytial growth pattern, and high-grade nuclei.[5] It is immunologically typically triple-negative, with negative estrogen receptors (ER), negative progesterone receptors (PR), and negative HER2/neu receptors.[3] There are also medullary breast carcinomas that are found to be estrogen receptors (ER) and/or progesterone receptor (PR) positive, making diagnosis less straightforward.
| Ridolfi Criteria | |
|---|---|
| 1. | Lymphoplasmacytic infiltration |
| 2. | Noninvasive microscopic circumscription |
| 3. | >75% syncytial growth pattern |
| 4. | High-grade nuclei |
Staging
TNM Staging is used to determine the extent of the disease and is used to guide the management and treatment of the cancer. It can be divided into Primary Tumor (T), Lymph Nodes (N), and Metastasis (M). The American Joint Committee on Cancer (AJCC) revised the staging system in 2018 to include the anatomic extent of the disease as well as prognostic biomarkers.[8]
| Primary Tumor (T) | |
|---|---|
| T0 | No primary tumor |
| Tis | Carcinoma in situ |
| T1 | Tumor is ≤2 cm |
| T2 | Tumor is >2 cm but ≤5 cm |
| T3 | Tumor is >5 cm |
| T4 | Tumor extends to chest wall or skin |
| Lymph Nodes (N) | |
|---|---|
| N0 | No lymph node metastasis |
| N1 | Metastasis to 1-3 axillary lymph nodes |
| N2 | Metastasis to 4-9 axillary lymph nodes |
| N3 | Metastasis to ≥10 axillary lymph nodes |
| Metastasis (M) | |
|---|---|
| M0 | No metastasis |
| M1 | Metastasis |
Prognostic biomarkers
- Estrogen receptor (ER), Progesterone receptor (PR), and HER2 receptor expression
- Histologic grade: Determined through the characteristics and features of tumor
- Recurrence score: Score <11 shows better prognosis
Management and treatment
Imaging
If breast cancer is suspected, imaging should be obtained through ultrasound, mammography, and/or MRI with appropriate biopsies.
Immunohistochemical testing
Immunological and histological testing should also be obtained for receptor status, which influences the type of treatment required. Since medullary breast carcinoma typically presents as triple negative, it may be treated with a more intensive chemotherapy regimen as with other triple negative breast cancers. This cancer has been found to respond well to chemotherapy compared to other breast cancers. Despite this, some cases of medullary breast carcinoma do not require chemotherapy for successful treatment. Depending on immunologic status, endocrine therapy can be utilized as well.[9]
Prognosis
Medullary breast carcinoma has a lower propensity to metastasize compared to other types of breast cancers. Compared to infiltrating ductal carcinomas, medullary breast carcinoma has a better prognosis and a significantly higher survival rate. The best measure of prognosis is through staging and axillary lymph node involvement in the absence of metastatic disease. The higher the involvement of lymph nodes, the worse the prognosis.[9] There is also an association between higher survival rates and chemotherapy response with the presence of lymphocytic infiltration.[10]
See also
References
- ^ Tominaga J, Hama H, Kimura N, Takahashi S (March 2008). "MR imaging of medullary carcinoma of the breast". Eur J Radiol. 70 (3): 525–9. doi:10.1016/j.ejrad.2008.01.044. PMID 18353587.
- ^ Bacus SS, Zelnick CR, Chin DM, et al. (December 1994). "Medullary carcinoma is associated with expression of intercellular adhesion molecule-1. Implication to its morphology and its clinical behavior". Am. J. Pathol. 145 (6): 1337–48. PMC 1887499. PMID 7992839.
- ^ a b Stelmach, Andrzej; Patla, Anna; Skotnicki, Piotr; Sas-Korczyńska, Beata (2017). "Typical medullary breast carcinoma: Clinical outcomes and treatment results". The Breast Journal. 23 (6): 770–771. doi:10.1111/tbj.12815. PMID 28421688. S2CID 206317489.
- ^ Kuroda H, Tamaru J, Sakamoto G, Ohnisi K, Itoyama S (January 2005). "Immunophenotype of lymphocytic infiltration in medullary carcinoma of the breast". Virchows Arch. 446 (1): 10–4. doi:10.1007/s00428-004-1143-9. PMID 15660281. S2CID 9517865.
- ^ a b c d Netra SM, Vani BR, Murthy VS (2018). "Cytomorphological Study of Medullary Carcinoma of Breast in Comparison to Infiltrating Ductal Carcinoma". J Cytol. 35 (4): 195–198. doi:10.4103/JOC.JOC_160_17. PMC 6210819. PMID 30498288.
{{cite journal}}: CS1 maint: multiple names: authors list (link) - ^ Nofal MN, Yousef AJ (December 2019). "The diagnosis of male breast cancer". The Netherlands Journal of Medicine. 77 (10): 356–359. PMID 31880271.
- ^ Armes, Jane E.; Venter, Deon J. (2002). "The pathology of inherited breast cancer". Pathology. 34 (4): 309–314. doi:10.1080/00313020220147113. PMID 12190286. S2CID 39886446.
- ^ AJCC Cancer Staging Manual. 2010. doi:10.1007/978-0-387-88441-7 (inactive 12 July 2025). ISBN 978-0-387-88440-0.
{{cite book}}: CS1 maint: DOI inactive as of July 2025 (link) - ^ a b Huober, J.; Gelber, S.; Goldhirsch, A.; Coates, A.S.; Viale, G.; Öhlschlegel, C.; Price, K.N.; Gelber, R.D.; Regan, M.M.; Thürlimann, B. (November 2012). "Prognosis of medullary breast cancer: analysis of 13 International Breast Cancer Study Group (IBCSG) trials". Annals of Oncology. 23 (11): 2843–2851. doi:10.1093/annonc/mds105. PMC 3477879. PMID 22707751.
- ^ Robbins and Cotran pathologic basis of disease. Vinay Kumar, Abul K. Abbas, Jon C. Aster, James A. Perkins (9th ed.). Philadelphia, PA: Elsevier/Saunders. 2015. ISBN 978-1-4557-2613-4. OCLC 879416939.
{{cite book}}: CS1 maint: others (link)
External links
- Medullary breast carcinoma entry in the public domain NCI Dictionary of Cancer Terms
![]() This article incorporates public domain material from Dictionary of Cancer Terms. U.S. National Cancer Institute.
This article incorporates public domain material from Dictionary of Cancer Terms. U.S. National Cancer Institute.